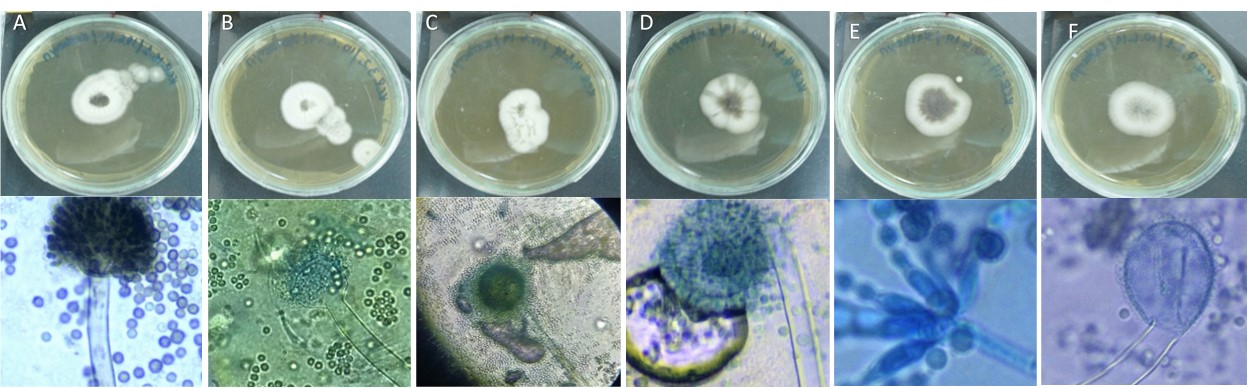
Caracter�sticas morfol�gicas de cepas f�ngicas aisladas de manglares. (A-F) las mejores im�genes muestran el crecimiento micelar en el medio de cultivo s�lido. A (KCR aislado 15.1); B (asylum KCR 3.2); C (KCR aislado 4.1 SP); D (KCR aislado 4.1.1); E (KCR 14 aislado); F (KCR aislado 7.2.1); en la imagen inferior se muestran las estructuras microsc�picas de aislados de hongos de manglares.

ARTICULO CIENTIFICO
PRIMER ESTUDIO DE DOS ESPECIES DE ASPERGILLUS AISLADAS DE BOSQUES DE MANGLAR EN ECUADOR
FIRST REPORT OF TWO ASPERGILLUS SPECIES ISOLATED FROM MANGROVE FOREST IN ECUADOR
PRIMER ESTUDIO DE DOS ESPECIES DE ASPERGILLUS AISLADAS DE BOSQUES DE MANGLAR EN ECUADOR
La Granja. Revista de Ciencias de la Vida, vol. 35, núm. 1, pp. 20-32, 2022
Universidad Politécnica Salesiana

Recepción: 14 Enero 2020
Aprobación: 08 Marzo 2021
Publicación: 01 Marzo 2022
Resumen: Los bosques de manglar están distribuidos en las zonas costeras de las regiones tropicales y subtropicales de todo el mundo, siendo especies tolerantes a altas temperaturas, humedad, mareas y las fluctuaciones salinas. Por lo tanto, se ven expuestos a múltiples fluctuaciones y condiciones ambientales extremas. El ecosistema de manglar no solo es hábitat de vida silvestre, sino que también es colonizado por diversas comunidades de microorganismos, como los hongos. Varios de estos hongos tienen múltiples funciones ecológicas, ya sea saprófitos o patógenos oportunistas. Actualmente el interés de estudiar estos microorganismos radica en su potencial biotecnológico dada su capacidad para tolerar ambientes hostiles. Ejemplo de ello son algunas especies del género Aspergillus, las cuales son utilizadas en biomedicina, industrial y la bioremediación. En el presente estudio se aislaron e identificaron de acuerdo con sus características morfológicas y moleculares especies de hongos del género Aspergillus. En este estudio se reportan los primeros aislados de Aspergillus niger y Aspergillus aculeatus de manglares en Ecuador. Investigaciones como ésta resaltan la importancia de determinar el rol de los hongos en el ecosistema de manglar.
Palabras clave: Manglar, Aspergillus niger, Aspergillus aculeatus, caracterización molecular.
Abstract: Mangroves forests are located in tropical and subtropical regions. The adaptation and distribution in coastal regions is influenced by temperature, humidity, tidal and saline fluctuations; therefore, there are exposed to multiple environmental fluctuations. Mangroves are inhabited by wildlife but also is supported by a diverse community of microorganisms, including fungi. Several fungi in mangroves have multiple ecological roles as saprotrophs or as an opportunistic pathogen, many of them are also used in the industry, as the genus Aspergillus, that are important inbiomedicine, industrial and environmental applications. In this study, we isolated species of fungi from mangrovestems and propagules. They were identified by both morphological and by its molecular characteristics. Here, we reportthe first isolated of Aspergillus niger and Aspergillus aculeatus from mangroves in Ecuador. Research such as these highlights the importance to determine the role of fungi in the mangrove ecosystem.
Keywords: Mangrove, Aspergillus niger, Aspergillus aculeatus, molecular characterization.
Forma sugerida de citar:
Sacheri-Viteri, K., Fernández-Cadena, J., Molina-Moreira, N. y Andrade-Molina, D. (2022). Primer estudio de dos especies de Aspergillus aisladas de bosques de manglar en Ecuador. La Granja: Revista de Ciencias de la Vida. Vol. 35(1):20-32. http://doi.org/10.17163/lgr.n35.2022.02.
1 Introducción
Los bosques de manglar son estuarios situados en regiones tropicales y subtropicales; este ecosistema se caracteriza por su alta tolerancia a la salinidad (Gopal y Chauhan, 2006). La distribución de manglares está fuertemente influenciada por la temperatura, la humedad, las corrientes de agua y las variaciones en el flujo de mareas y vientos; y junto con la alta abundancia y variedad de microorganismos se convierte en un importante ecotono dinámico entre el medio ambiente terrestre y marino (Sridhar, Roy y Sudeheep, 2011). Teniendo en cuenta los microorganismos, los hongos descomponen significativamente la materia orgánica y desempeñan un papel fundamental en la productividad y biodiversidad de este ecosistema (Friggens, Taylor y Koukol, 2017). Los hongos que habitan en los bosques de manglar son saprofitos, simbiontes o parásitos, tanto en filamentos como en levadura (Rodríguez y col., 2013). Estos hongos pueden colonizar raíces, tallos y ramas sumergidas en el agua o se pueden encontrar en la superficie del agua (Li y col., 2016). La diversidad de hongos depende del metabolismo ya que en los estratos se asocia con cambios diarios en la salinidad, e inundaciones intermitentes debido a la marea, exposición a la niebla de sal y disponibilidad de sustratos (Hrudayanath, Bikash y Rashmi, 2013).
Las actividades humanas constituyen el principal problema para los manglares; entre las principales actividades humanas están la destrucción de hábitats, la contaminación y la sobreexplotación de los recursos (Díaz, 2011). Muchas ciudades se han asentado cerca de los manglares, por lo que están constantemente expuestos a la contaminación que está formada por actividades antropogénicas y a una variedad de productos químicos, incluyendo metales pesados que se consideran un grave problema para el ecosistema de manglares, ya que se acumulan en la superficie de los sedimentos, aumentando su concentración en la zona (Fernández y col., 2014).
Los géneros más comunes de hongos aislados de los manglares Rhizophora spp. son Aspergillus, Aureobasidium, Cladosporium, Curvularia, Cylindrocephalum, Drechslera, Fusarium, Myrothecium, Nigrospora, Penicillium, Pestalotia, Phyllosticta, Trichoderma y Verticilium (Sarma, 2012). Sin embargo, pocos estudios describen el papel de estos hongos en el ecosistema de manglares. La mayoría de los hongos identificados en los ecosistemas de manglares son endófitos; estos hongos son muy importantes ya que han sido capaces de producir metabolitos bioactivos para modificar los mecanismos de defensa de su huésped, permitiendo que ambos subsistan en el medio ambiente (Sánchez y col., 2013). Varios hongos (por ejemplo, Aspergillus, Absidia, Cunninghamella, Mucor y Rhizopus) son capaces de acumular metales pesados en sus compartimentos celulares, ofreciendo una alternativa en biorremediación de áreas contaminadas a bajo costo, en comparación con los métodos tradicionales de descontaminación (Cardoso y col., 2010).
En muchos casos, los bosques de manglares están formados por monocultivos naturales de alta densidad, donde los árboles están constantemente expuestos a patógenos (Ramírez, Serrano y Sandoval, 2006). Sin embargo, los registros fitopatógenos en los ecosistemas de manglares son escasos (Pan y col., 2018).
La mayoría de los hongos que colonizan los manglares pertenecen al grupo Ascomycota, y varias especies parasitarias pertenecientes a este grupo pueden producir la muerte de las plantas (Pan y col., 2018). Aunque la relación entre la diversidad fúngica y los manglares no está clara, se sabe que los hongos marinos son responsables de la descomposición de la madera de manglar en las especies más comunes, incluyendo Rhizophora y han sido descritos como una biomasa digerible más eficiente que las bacterias (Steinke y Jones, 1993; Kathiresan y col., 2011). El género Fungus Trichoderma y Traustreochystrids son saprofitas eficientes debido a la actividad enzimática, y es un microorganismo potencial a la celulosa degradada, almidón, lípidos, proteínas y lignina; mientras que Thichosporon, Fusarium y Aspergillus presentaron la actividad máxima de celulasa y proteasa en las hojas de manglares (Kathiresan y col., 2011).
El Aspergillus está ampliamente distribuido en la naturaleza debido a la fácil dispersión de sus conidios y su pequeño tamaño; esto les permite permanecer en el medio ambiente durante un largo tiempo (Abarca, 2000). El género Aspergillus es muy interesante pues es muy completo, abarca desde fábricas de células industriales, organismos modelo y patógenos humanos, pues tiene una producción prolífica de metabolitos secundarios bioactivos (Kjærbølling y col., 2018). Estos hongos son importantes en la descomposición de la materia orgánica y en la defensa del huésped contra microorganismos altamente patógenos (Ramírez, Serrano y Sandoval, 2006). Las aplicaciones de estos hongos son necesarias para mejorar los futuros estudios llevados a cabo en ómicos (Shu-Lei y col., 2020). Este estudio constituye el primer reporte de dos especies de Aspergillus aisladas de manglares en Ecuador e identifica sus características moleculares y morfológicas.
2 Materiales y Métodos
2.1 Área de muestreo y recolección
El Parque Histórico de Guayaquil - PHG (Parque Histórico de Guayaquil) es un remanente de bosque de manglares ubicado en la ciudad de Samborondón, Ecuador. Se identificaron lesiones con síntomas asociados con la presencia de hongos en las ramas, posteriormente se recolectaron y se almacenaron en bolsas herméticas para su posterior análisis.
2.2 Caracterización morfológica de las muestras de hongos
La caracterización morfológica se realizó en cultivos con evidente estructura reproductiva o en cepas con más de 20 días de tiempo de cultivo. El micelio se separó usando cinta adhesiva y se colocó en una lámina con una gota de lactofenol, y luego se selló con un cubreobjetos. La visualización de las estructuras se realizó en un microscopio óptico Nikon Eclipse E100 con una cámara digital integrada. Para determinar la afiliación taxonómica, se utilizaron tanto la base de datos del micobanco (http://mycobank.org) como las claves taxonómicas (Hoog y col., 2001).
2.3 Aislamiento y purificación de los hongos
El material vegetal se desinfectó con un 1% de hipoclorito de sodio con lavados repetidos usando agua estéril. Posteriormente se cortaron fragmentos con un bisturí estéril y se depositaron en medios de cultivo ASD (Sabouraud Dextrosa Agar, OXOID), complementados con 15 µg/ml de cloranfenicol para el aislamiento y la diferenciación de los hongos. Las placas de cultivo se incubaron a temperatura ambiente y en completa oscuridad hasta que se observó el crecimiento micelar. Este proceso se repitió hasta que se obtuvieron aislados puros. Las muestras previamente aisladas fueron inoculadas en 150 ml de medio de cultivo líquido PW (peptona agua, CRITERIO y caldo nutritivo) complementadas con 15 ng/ml de cloranfenicol e incubadas durante 15 a 20 días hasta que apareció la biomasa. El micelio se filtró utilizando unidades de filtración estériles, y la biomasa se secó a 42 °C durante dos días y se almacenó a −80 °C hasta su posterior análisis.
2.4 Extracción de ADN
El material fúngico fue incubado con lisozima (10 µg/mL) a 37 °C durante dos horas. La extracción de ADN se realizó utilizando los kits de aislamiento de ADN del suelo (QIAGEN, Carlsbad, EE.UU.) con las siguientes modificaciones: Los hongos se secaron previamente y congelaron a −80 °C y luego se transfirieron a los tubos de Powerbead, este material fue mezclado por vórtice durante tres minutos. Posteriormente, se añadieron 60 µL de tampón C1 y se realizó un vórtice durante otros tres minutos, luego se añadieron 20 µL de proteinasa K y se mezclaron con vórtice durante 1 minuto. La mezcla se centrifugó a 8.000 rpm 1 minuto, el sobrenadante se rescató en un nuevo tubo de eppendorf y se añadieron 250 µL de tampón C2, luego se mezcló nuevamente durante 5 segundos y se incubó a −20 °C durante 5 minutos. Las muestras se centrifugaron a temperatura ambiente a 8.000 rpm durante 1 minuto y el sobrenadante se transfirió a un nuevo tubo, posteriormente, se añadieron 200 µL de solución C3, se agitaron durante 1 minuto e incubaron a −20 °C durante 5 minutos.
Para el aislamiento del ADN, las muestras se centrifugaron a 8.000 rpm durante 1 minuto y el sobrenadante se transfirió a un nuevo tubo con 1 ml de solución C4. La mezcla se centrifugó a 8.000 rpm durante 1 minuto, luego se añadieron 500 µL de solución C5 y se centrifugaron a 8.000 rpm durante 1 minuto. Para eluir el DBA, se añadieron 100 µL de agua ultrapura al centro de la columna, se centrifugó a 13.000 rpm durante 1 minuto y se almacenó a −20 °C hasta su posterior uso. La integridad del ADN se evaluó mediante electroforesis de gel de agarosa al 1% en tampón TAE 1X (Tris, Acetato, EDTA) complementado con un núcleo verde SyBR (Invitrogen), comparando la intensidad y la banda del peso molecular del ADN con 100 bp (Tracklit Invitrogen). Las condiciones de electroforesis se realizaron a 100 voltios y 35 miliamperios.
2.5 Amplificación de las regiones ITS-1 e ITS-2 por reacción en cadena de polimerasa (PCR)
Después de la extracción del ADN, se identificaron los hongos a nivel de género o especie a partir de la amplificación de las regiones intergénicas de rADN utilizando ITS-1 (TCCGTAGGTGAACCTGCGG) y primers universales ITS-4 (TCCTCCGCTTATTGATATGC) (White y col., 1990). Las condiciones de PCR se realizaron en un volumen final de 30 µL con una concentración final de 2.5 mM MgCl2; 2 µM primers; 2 U taq pol y tampón 1X PCR. El programa incluye desnaturalización a 95 °C durante 5 minutos, seguido de 35 ciclos de 94 °C durante 59 segundos, 50 °C por segundos y extensión a 72 °C durante 1 minuto, con una extensión final de 72 °C durante 10 minutos.
2.6 Análisis de secuencias
Los amplificadores purificados se secuenciaron en Macrogen (Corea del Sur) y se editaron en Geneious Prime Software (versión 2019.1), con el fin de obtener una secuencia. La afiliación taxonómica se llevó a cabo usando el algoritmo de alineación BLAST (https://blast.ncbi.nlm.nih.gov/Blast.cgi). De igual forma, el análisis filogenético se reforzó utilizando el algoritmo Clustal W y Geneious Prime Software. Se generó un árbol por Neighbor Join (Saitou y Nei, 1987) y se utilizó el modelo a distancia de Kimura (Kimura, 1983) usando el software MEGA 7, con con un bootstrap de 1000 repeticiones y eliminando información faltante. Los resultados se muestran usando iTOL (Letunic y Bork, 2016). Las secuencias ITS relacionadas con Aspergillus y registradas en la base de datos NCBI, utilizada en esta investigación, se presentan en la Tabla complementaria 1A. El teleomorfo de Aspergillus sp. utilizado en este estudio fue Emiricella nidulans (HQ026740.1), la resolución de los árboles se optimizó usando Aspergillus elegans (NR077196.1 y MH992144.1), y el grupo alternativo fue Saccharomyces cerevisiae (MG775707.1).
3 Resultados
Dentro de los sustratos recogidos en el presente estudio se analizaron lesiones supuestamente causadas por hongos (Figura 1). De esta planta, se aislaron y se purificaron desde las ramas cinco cepas de hongos y una cepa aislada de los propágulos (Tabla 1), y en el momento de crecer en el medio de cultivo sólido, se formó un micelio blanco y más tarde se volvió negro o gris, con un micelio hundido (Figura 2 a-f). Al observar las características microscópicas, se determinó que estos aislados tienen una hifa lisa, con vesículas esféricas cubiertas por filias y conidios esféricos (Figura 2 h-l). Teniendo en cuenta las características macro y microscópicas, la clasificación clásica se realizó mediante el uso de claves taxonómicas (Hoog y col., 2001) y la base de datos Mycobank (http://mycobank.org). Como resultado, estos hongos pertenecen al género Aspergillus pero por el análisis ITS, los KCR3.2, KCR4.1sp y KCR15.1 corresponden a Aspergillus niger, mientras que los KCR4.1.1., KCR7.2.1. y KCR14 están relacionados con Aspergillus aculeatus.
De todas las 90 secuencias de nucleótidos, se utilizaron 438 posiciones en la región ITS en el análisis filogenético. A primera vista, todas las especies analizadas en este estudio pertenecen a la sección Nigri (Gams y col., 1986). El análisis es compatible con un Bootstrap con 1000 repeticiones y por el algoritmo “Neighbor Joining”. El árbol muestra clados bien diferenciados y desarrollados entre especies de hongos en los grupos A.niger y A. tubingensis y entre A. aculeatus y A. japonicus (Figura 3). El dendrograma muestra que tanto A. niger como A. tubingensis serían la misma especie, esto también se observa entre A. aculeatus y A. japonicus.
Como se muestra en la Tabla 2, A. niger y A. tubingensis son similares en 89.6% en la alineación más grande con el tamaño 3 626 085 bp, y la similitud entre A. aculeatus y A. japonicus es de 90.9% con la alineación más grande de 3 727 362 bp,. Esto demuestra que están muy cerca el uno del otro, pero también difieren con los miembros de otros clados (es decir, A. niger y A. japonicus son similares en un 78.3%).

A primera vista, se puede ver filogenéticamente que la región ITS no funciona bien en la resolución de grupos de hongos. Para obtener resultados satisfactorios, es necesario complementar estos análisis con la identificación morfológica y, en este caso, realizar una comparación entre genomas.
4 Discusión
En Ecuador, este estudio resulta de gran importancia pues sirve como una base del enfoque de micobioma en la identificación de hongos en los manglares. Se identificaron y purificaron dos especies de Aspergillus, A. niger y A. aculeatus, que habían sido reportadas en otros bosques de manglares en Malasia, México, China e Indonesia (Sathiya y col., 2009; Deng y col., 2013; Li y col., 2017; LumbrerasMartínez y col., 2018; Prihanto, Caisariyo y Pradarameswari, 2019). A pesar de que los hongos están ampliamente distribuidos en los árboles de los manglares, algunos de ellos cumplen con funciones ecológicas y fisiológicas para aumentar la tolerancia a las condiciones de estrés biótico y abiótico (ShuLei y col., 2020). Los estudios sobre la diversidad de hongos en manglares se centran principalmente en hongos cultivables, pero son muy escasos los que estudian los hongos nativos no cultivables.
Tradicionalmente, la identificación, taxonomía y clasificación de Aspergillus se había concentrado a las características morfológicas (Patki, Singh y Mehta, 2015). Sin embargo, la clasificación taxonómica basada en la caracterización molecular se convirtió en herramienta esencial, pues permite distinguir las características filogenéticas (Samson y col., 2014).

Un trabajo publicado anteriormente sobre la relación filogenética de Aspergillus indicó que, aunque la amplificación de las regiones ITS fue aceptada como código de ADN para hongos en general (Conrad y col., 2012), el análisis filogenético no fue resolutivo para distinguir los clados uniseriados en la sección Nigri, especialmente al agregar las secuencias de A. niger, lo que podría conducir a una identificación errónea de las especies (Abarca, 2000; Perrone y col., 2008). Nuestros resultados son consistentes con muchas de las investigaciones. Las especies A. aculeatus y A. japonicus fueron filogenéticamente similares, al igual que A. niger y A. tubingensis. Esto también explica las pequeñas diferencias entre algunas especies pertenecientes a la sección Nigri, la especie A. niger sensu stricto, A. tubingensis, A. foetidus, y A. brasiliensis son morfológicamente idénticas y en conjunto se han llamado A. niger (Munique y col., 2009). Esto también coincide con lo reportado por Yokoyama y col. (2001) quienes describen que la mayoría de las especies de la sección Nigri son morfológicamente similares y la identificación molecular por mtADN y rADN ha sido confusa.
Las técnicas moleculares resueltas básicas como RFLP, AFLP, PFGE o la secuenciación de próxima generación - NGS mejorarían significativamente el conocimiento y la comprensión de este hongo (Leong y col., 2006; Perrone y col., 2008; Quainoo y col., 2017). De igual forma, la comparación del genoma ofrece la mejor resolución para determinar los porcentajes de similitud entre las secuencias (Quainoo y col., 2017). En este estudio realizamos la comparación de similitud genética para determinar la diversidad genética entre A. niger, A. fumigatus y entre A. aculeatus y A. japonicus. Los resultados mostraron una alta similitud con una identidad media de nucleótidos (ANI) de aproximadamente el 90% de la especie analizada (Tabla 2). Estos resultados se pueden utilizar para explicar muchos aspectos, como el linaje de fondo de la cepa que muestra que este enfoque es altamente útil para los nuevos genetistas fúngicos.
Se ha demostrado que Aspergillus sp. está ampliamente distribuido en el medio ambiente, y es considerado como uno de los fitopatógenos más frecuentes, ya que su capacidad para producir toxinas altera el metabolismo de las plantas (Pavón y col., 2012). Algunos de estos hongos colonizan las raíces, facilitando su crecimiento y mejorando la calidad del pasto. Otras características son la solubilización del fósforo, la tolerancia del halo, y la acentuación del estrés salino a las plantas (Li y col., 2017).

Aspergillus se caracteriza por producir micotoxinas y metabolitos secundarios que son importantes en la degradación de la materia orgánica y sirven como mecanismos de defensa hacia otros microorganismos (Pavón y col., 2012).
La importancia de este estudio también se basa en la capacidad biotecnológica que puede ofrecer el ecosistema de manglares y su componente microbiano. Una de estas se refiere a las características fisiológicas que los hongos presentan con la producción de proteínas específicas, por ejemplo, los metabolitos para inhibir el crecimiento celular de otros microorganismos en un entorno de alta salinidad (Nicoletti, Salvatore y Andolfi, 2018). También se ha demostrado que algunos Aspergillus sp. ayudan en los procesos de biorremediación de entornos contaminados por metales pesados, degradación de la celulosa extracelular y hemicelulosa (Marrero, Amores y Coto, 2012; Huachi, Macas y Méndez, 2014; Araujo y col., 2016).
A. niger se ha utilizado ampliamente para obtener enzimas tales como: α-amilasa, catalasa, celulasa, hemicelulasa, lipasa y ácidos orgánicos que podrían ser una alternativa para reemplazar los petroquímicos (Patki, Singh y Mehta, 2015; Ameen y col., 2016; Wang y col., 2016; Morthensen y col., 2017; Wang y col., 2019; Nascimento y col., 2019; Hossain y col., 2016). También se utiliza para los procesos de producción de ácido cítrico que se llevan a cabo por estado sólido, fermentación sumergida y superficial (López y col., 2006). A. niger , que se empezó a usar en la industria de la fermentación bioquímica y en la biotecnología industrial, produce una amplia gama de proteínas, enzimas y segundos metabolitos (Cairns, Nai y Meyer, 2018).
La importancia de A. niger para el medio ambiente se basa en su capacidad para bioacumular metales tóxicos (plomo, cadmio, cobre y cromo) (Rivera y col., 2015). Varios estudios han demostrado que A. niger tiene mayor capacidad para eliminar compuestos fenólicos, aceite de suelos contaminados y metales pesados, que el carbón activo granular, utilizado en varios ciclos de biosorpción (Araujo y col., 2016; Marzan y col., 2017; Villalba, Cruz y Azuara, 2018). (Ghyadh, Al e Ibrahim, 2019) señaló que el hongo Aspergillus niger mostró en un 100% la mayor eficiencia en la reducción de las concentraciones de elementos pesados.
Aspergillus aculeatus mostró una alta resistencia a la toxicidad del cadmio (CD), protegió el fotosistema II contra el estrés de CD y aumentó la eficiencia del proceso de fotosíntesis en el cesped inglés perenne. Estos resultados sugieren que A. aculeatus podría ser útil para pretratar suelos contaminados con CD (Han y col., 2018). También tiene un efecto importante en la atenuación del estrés salino ya que produce ácido indole-3-acético y sideróforos que confieren tolerancia de estrés salino a las plantas (Li y col., 2017).
La investigación sobre la capacidad metabólica de A. niger y A. aculeatus y su interacción con iones metálicos son limitadas (Emri y col., 2018). Aunque existen estudios sobre diferentes especies de Aspergillus en manglares, los informes sobre niger y aculeatus son escasos o nulos. Además, la mayoría de los estudios se centran en el potencial biotecnológico y biorremedial. Las especies de Aspergillus reducen las altas concentraciones de metales pesados, pero también producen un gran número de micotoxinas y metabolismo secundario, y pueden ser capaces de producir una gran parte de compuestos bioactivos que se utilizan en la industria farmacéutica (Frisvad y col., 2018; Shu-Lei y col., 2020). Se necesitan llevar a cabo más investigaciones sobre las especies de Aspergillus y sus aplicaciones para producir diferentes metabolitos secundarios bioactivos.
Los estudios exploratorios como los realizados en este trabajo permiten obtener nueva información sobre la participación de hongos en los ecosistemas de manglares, además de evaluar sus posibles roles como protectores para sus huéspedes o determinar si se trata de hongos patógenos que causan deterioro y descomposición de la madera en los manglares. Brevemente, este estudio se centró en el hongo endofítico, convirtiéndolo en un candidato potencial para futuras investigaciones. Por lo tanto, la diversidad de hongos en los ecosistemas de manglares es necesaria a partir de la secuenciación de genomas, ya que puede representar una estrategia útil para encontrar nuevas vías metabólicas y, posteriormente, nuevos compuestos y enzimas bioactivas.
5 Conclusiones
En este estudio reportamos la caracterización molecular y morfológica del hongo aislado de manglares pertenecientes al clado Nigri, el Aspergillus niger y el Aspergillus aculeatus. Este trabajo es un esfuerzo para entender la distribución de especies de hongos y destacar la importancia de determinar el papel del hongo en el ecosistema de manglares.
Agradecimientos
Los autores agradecen el apoyo financiero brindado por el Centro de Investigaciones (CIN), Universidad Espíritu Santo, a los proyectos registrados bajo el número 2018MED001 y 2018ART006.
Referencias
Abarca, M. (2000). «Taxonomía e identificación de especies implicadas en la aspergilosis nosocomial». En: Rev Iberoam Micol 17.3, S79-S84. Online: https://bit.ly/34C1Uyz.
Ameen, F. y col. (2016). «Biodegradation of diesel fuel hydrocarbons by mangrove fungi from Red Sea Coast of Saudi Arabia». En: Saudi journal of biological sciences 23.2, 211-218. Online: https:// bit.ly/3uJAAZT.
Araujo, J. y col. (2016). «Microanálisis de una cepa de Aspergillus niger biocatalizadora de hidrocarburos policíclicos aromáticos HPA». En: Acta Microscopica 25.2, 98-110. Online: https://bit.ly/3uFJRCb.
Cairns, T., C. Nai y V. Meyer (2018). «How a fungus shapes biotechnology: 100 years of Aspergillus niger research». En: Fungal biology and biotechnology 5.1, 1-14. Online: https://bit.ly/3pdzowx.
Cardoso, A. y col. (2010). «Microorganisms in Industry and Environment». En: Scientific e Industrial Research to Consumer Products. Cap. Influence of the heavy metals on chitosan production by Absidia corymbifera UCP 0134, 176-180. Online: https://bit.ly/2TBgTGQ.
Conrad, S. y col. (2012). «Nuclear ribosomal internal transcribed spacer (ITS) region as a universal DNA barcode marker for Fungi». En: Proceedings of the National Academy of Sciences 109.16, págs. 6241-6246.
Deng, C. M. y col. (2013). «Secondary metabolites of a mangrove endophytic fungus Aspergillus terreus (No. GX7-3B) from the South China Sea». En: Marine Drugs 7.11, 2616–2624. Online:https://bit.ly/3izeia1.
Díaz, M. (2011). «Una revisión sobre los manglares: características, problemáticas y su marco jurídico. Importancia de los manglares, el daño de los efectos antropogénicos y su marco jurídico: caso sistema lagunar de Topolobampo». En: Ra Ximhai: revista científica de sociedad, cultura y desarrollo sostenible 7.3, 355-369. Online: https://bit.ly/3wVdrFv.
Emri, T. y col. (2018). «Duplications and losses of genes encoding known elements of the stress defence system of the Aspergilli contribute to the evolution of these filamentous fungi but do not directly influence their environmental stress tolerance». En: Studies in mycology 91, 23-36. Online: https://bit.ly/3fUMric.
Fernández, J. y col. (2014). «Heavy metal concentration in mangrove surface sediments from the north-west coast of South America». En: Marine pollution bulletin 82.1-2, 221-226. Online: https: //bit.ly/3fGWcSj.
Friggens, N., J. Taylor y O. Koukol (2017). «Diversity and community composition of aquatic ascomycetes varies between freshwater, estuarine and marine habitats in western Scotland». En: Mycosphere 8.9, 1267-1287. Online: https://bit.ly/3pa1FnM.
Frisvad, J. y col. (2018). «Safety of the fungal workhorses of industrial biotechnology: update on the mycotoxin and secondary metabolite potential of Aspergillus niger, Aspergillus oryzae, and Trichoderma reesei». En: Applied Microbiology and Biotechnology 102.22, 9481-9515. Online: https:// bit.ly/3fEbnvF.
Gams, W. y col. (1986). «Advances in Penicillium and Aspergillus systematics». En: Plenum Press. Cap. Infrageneric taxa of Aspergillus, 55-62. Online: https://bit.ly/3yNZXwO.
Ghyadh, B., A. Al y Z. Ibrahim (2019). «Biotechnology of wastewater treatment with fungi (Aspergillus niger and Rhizopus oligosporium).» En: Plant Archives 19.2, 1546-1549. Online: https://bit.ly/2RfcM2o.
Gopal, B. y M. Chauhan (2006). «Biodiversity and its conservation in the Sundarban Mangrove Ecosystem». En: Aquatic Sciences 68.3, 338-354. Online: https://bit.ly/3A20EmU.
Han, S. y col. (2018). «Cadmium tolerance of perennial ryegrass induced by Aspergillus aculeatus». En: Frontiers in microbiology 9, 1579. Online: https://bit.ly/3g3RrRW.
Hoog, G. de y col. (2001). Atlas of clinical fungi. Central bureau voor Schimmelcultures.
Hossain, A. y col. (2016). «Rewiring a secondary metabolite pathway towards itaconic acid production in Aspergillus niger». En: Microbial cell factories 15.1, 1-15. Online: https://bit.ly/3g5YUzV.
Hrudayanath, T., C. B. Bikash y R. M. Rashmi (2013). «Ecological role and biotechnological potential of mangrove fungi: a review». En: Mycology 4, págs. 54-71.
Huachi, L., Á. Macas y G. Méndez (2014). «Biodegradación de los fenoles presentes en el extracto de guarango (Caesalpinia spinosa) y en los colorantes indigo carmín, naranja II y rojo fenol a través de Trametes versicolor y Aspergillus niger». En: La Granja 20.2, 29-35. Online: https://bit.ly/2RToFvj.
Kathiresan, K. y col. (2011). «Microbial enzyme activity in decomposing leaves of mangroves». En: International Journal of Advanced Biotechnology and Research 2.3, 382-389. Online: https://bit.ly/3zX1Fg9.
Kimura, M. (1983). The neutral theory of molecular evolution. Cambridge University Press.
Kjærbølling, I. y col. (2018). «Linking secondary metabolites to gene clusters through genome sequencing of six diverse Aspergillus species». En: Proceedings of the National Academy of Sciences 115.4, E753-E761. Online: https://bit.ly/3p8GwdO.
Leong, K. y col. (2006). «The use of text messaging to improve attendance in primary care: a randomized controlled trial». En: Family practice 23.6, 699-705. Online: https://bit.ly/3cymxjN.
Letunic, I. y P. Bork (2016). «Interactive tree of life (iTOL) v3: an online tool for the display and annotation of phylogenetic and other trees». En: Nucleic acids research 44.W1, W242-W245. Online: https://bit.ly/3wVSVEq.
Li, J. y col. (2016). «Community structure of endophytic fungi of four mangrove species in Southern China». En: Mycology 7.4, 180-190. Online: https://bit.ly/3ieRHQF.
Li, X. y col. (2017). «The fungus Aspergillus aculeatus enhances salt-stress tolerance, metabolite accumulation, and improves forage quality in perennial ryegrass». En: Frontiers in microbiology 8, 1664. Online: https://bit.ly/3g8VP1P.
López, C. y col. (2006). «Producción de ácido cítrico con Aspergillus niger NRRL 2270 a partir de suero de leche». En: Dyna 73.150, 39-57. Online: https://bit.ly/34CxQ5R.
Lumbreras-Martínez, H. y col. (2018). «Bioprospecting of fungi with antiproliferative activity from the mangrove sediment of the Tampamachoco coastal lagoon, Veracruz, Mexico». En: Scientia fungorum 48, págs. 53-60.
Marrero, J., I. Amores y O. Coto (2012). «Fitorremediación, una tecnología que involucra a plantas y microorganismos en el saneamiento ambiental». En: ICIDCA. Sobre los Derivados de la Caña de Azúcar 46.3, 52-61. Online: https://bit.ly/3g61uGa.
Marzan, L. y col. (2017). «Isolation and biochemical characterization of heavy-metal resistant bacteria from tannery effluent in Chittagong city, Bangladesh: Bioremediation viewpoint». En: The Egyptian Journal of Aquatic Research 43.1, 65-74. Online: https://bit.ly/3icuG0M.
Morthensen, S. y col. (2017). «Significance of membrane bioreactor design on the biocatalytic performance of glucose oxidase and catalase: Free vs. immobilized enzyme systems». En: Biochemical Engineering Journal 117, 41-47. Online: https: //bit.ly/3g5xFoZ.
Munique, L. y col. (2009). «Genetic relationships among strains of the Aspergillus niger aggregate». En: Brazilian Archives of Biology and Technology 52.52(sep), 241-248. Online: https://bit.ly/3fZmuyd.
Nascimento, P. A. y col. (2019). «Effects of cholinium-based ionic liquids on Aspergillus niger lipase: stabilizers or inhibitors». En: Biotechnology Progress 5.35, e2838.
Nicoletti, R., M. Salvatore y A. Andolfi (2018). «Secondary metabolites of mangrove-associated strains of Talaromyces». En: Marine Drugs 16.1, 12. Online: https://bit.ly/3vR0RXF.
Pan, M. y col. (2018). «Cytospora pice ae sp. nov. associated with canker disease of Picea crassifolia in China». En: Phytotaxa 383.2, 181-196. Online: https://bit.ly/2UKXaFn.
Patki, J., S. Singh y S. Mehta (2015). «Partial purification and characterization of phytase from bacteria inhabiting the mangroves of the western coast of India». En: Int. J. Curr. Microbiol. App. Sci 4.9, 156-169. Online: https://bit.ly/2TEfgIu.
Pavón, M. y col. (2012). «Importancia del género Alternaria como productor de micotoxinas y agente causal de enfermedades humanas». En: Nutrición Hospitalaria 27.6, 1772-1781. Online: https: //bit.ly/3xTvf48.
Perrone, G. y col. (2008). «Aspergillus in the genomic era». En: Wageningen Academic Publishers. Cap. Aspergilli in the biotechnology and agriculture, págs. 179-2013.
Prihanto, A. A., I. O. Caisariyo y K. A. Pradarameswari (2019). «Aspergillus sp. as a potential producer for L-Asparaginase from mangrove (Avicennia germinans)». En: IOP Conference Series: Earth and Environmental Science 230.1, pág. 012101.
Quainoo, S. y col. (2017). «Whole-genome sequencing of bacterial pathogens: the future of nosocomial outbreak analysis». En: Clinical microbiology reviews 30.4, 1015. Online: https://bit.ly/3pmun5c.
Ramírez, Ninfa, José Antonio Serrano y Horacio Sandoval (2006). «Microorganismos extremófilos. Actinomicetos halófilos en México». En: Revista Mexicana de Ciencias Farmacéuticas 37.3, págs. 56-71.
Rivera, E. y col. (2015). «Remoción de Cromo (VI) por una Cepa de Aspergillus niger Resistente a Cromato». En: Información tecnológica 26.4, 13-20. Online: https://bit.ly/3jlMtmH.
Rodríguez, M. y col. (2013). Manglares de México/Extensión, distribución y monitoreo. Comisión Nacional para el Conocimiento y Uso de la Biodiversidad. Online: https://bit.ly/3fLwo7M.
Saitou, N. y M. Nei (1987). «The neighbor-joining method: a new method for reconstructing phylogenetic trees.» En: Molecular biology and evolution 4.4, 406-425. Online: https://bit.ly/3zZs6S9.
Samson, R. y col. (2014). «Phylogeny, identification and nomenclature of the genus Aspergillus». En: Studies in mycology 78, 141-173. Online: https:// bit.ly/3fOKCoa.
Sánchez, R. y col. (2013). «Hongos endófitos: fuente potencial de metabolitos secundarios bioactivos con utilidad en agricultura y medicina». En: TIP Revista especializada en Ciencias QuímicoBiológicas 16.2, 132-146. Online: https://bit.ly/ 2Rlsedf.
Sarma, V. (2012). «Diversity and distribution of marine fungi on Rhizophora spp. in mangroves». En: Biology of Marine Fungi, 243-275. Online: https: //bit.ly/3g6LljM.
Sathiya, P. y col. (2009). «Optimization of friction welding parameters using evolutionary computational techniques». En: Journal of materials processing technology 209.5, 2576-2584. Online: https: //bit.ly/2Rp2QU6.
Shu-Lei, J. y col. (2020). «Fungi in mangrove ecosystems and their potential applications». En: Critical Reviews in Biotechnology 40.6, 852-864. Online: https://bit.ly/3g6VvAX.
Sridhar, K., S. Roy y N. Sudeheep (2011). «Assemblage and diversity of arbuscular mycorrhizal fungi in mangrove plant species of the southwest coast of India». En: Mangroves ecology, biology and taxonomy, 257-274. Online: https://bit. ly/3i8UHOm.
Steinke, T. y E. Jones (1993). «Marine and mangrove fungi from the Indian Ocean coast of South Africa». En: South African Journal of Botany 59.4, 385-390. Online: https://bit.ly/3A0tUKI.
Villalba, A., M. Cruz y G. Azuara (2018). «Aspergillus niger Tiegh., isolated in Sonora, Mexico: metal tolerance evaluation». En: Revista Chapingo serie ciencias forestales y del ambiente 24.2, 131-146. Online: https://bit.ly/3xTDVaM.
Wang, J. y col. (2019). «Delignification overmatches hemicellulose removal for improving hydrolysis of wheat straw using the enzyme cocktail from Aspergillus niger». En: Bioresource technology 274, 459-467. Online: https://bit.ly/34HVjTo.
Wang, S. y col. (2016). «Characterization of a starchhydrolyzing α-amylase produced by Aspergillus niger WLB42 mutated by ethyl methanesulfonate treatment». En: International journal of biochemistry and molecular biology 7.1, 1. Online: https: //bit.ly/3yai2nV.
White, T.J. y col. (1990). «PCR Protocols: a guide to methods and applications». En: ed. por M.A. Innis y col. New York, USA: Academic Press. Cap. Amplification and direct sequencing of fungal ribosomal RNA genes for phylogenetics, 315–322.
Yokoyama, K. y col. (2001). «Identification, classification and phylogeny of the Aspergillus section Nigri inferred from mitochondrial cytochrome b gene». En: FEMS Microbiology Letters 200.2, 241-246. Online: https://bit.ly/3h7y3nF.
Apéndice
Tabla 1. A: Lista del número de especies de acceso de GenBank utilizadas en el presente estudio.

Enlace alternativo
https://revistas.ups.edu.ec/index.php/granja/article/view/3650 (html)